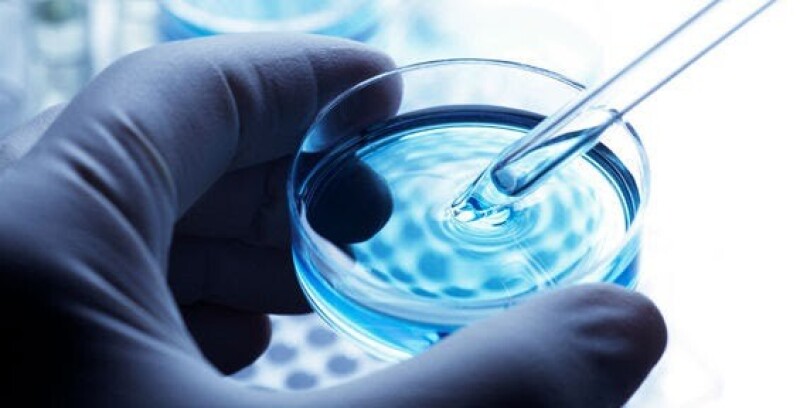

Люди по-різному ставляться до дітей, до можливості або неможливості їх народити. Деякі
спокійно сприймають діагноз «безпліддя», для інших він стає трагедією всього життя, точніше, раніше ставав.
На щастя, зараз завдяки допоміжним репродуктивним технікам (ДРТ) безпліддя більше не є ані трагедією, ані вироком. Практично кожна пара має шанс на щасливе батьківство, навіть якщо безплідні обидва партнери.
Екстракорпоральне запліднення
Екстракорпоральне, або штучне запліднення, — один з методів ДРТ, що дає змогу завагітніти жінкам з деякими видами безпліддя.
За екстракорпорального запліднення у жінки вилучається яйцеклітина, бажано не одна, а кілька, а в чоловіка береться сперма. Після підготовки вони з’єднуються в спеціальному лабораторному посуді (звідси народна назва методу — зачаття «в пробірці»).
Посуд поміщають у термостат, температура в якому відповідає температурі тіла. Через деякий час запліднені яйцеклітини, тобто вже ембріони, виділяють з культури та імплантують в матку. Завдання ембріона — прикріпитися до стінки матки.
Якщо у нього це вийшло, вагітність є такою, що відбулася, і далі розвивається як звичайна, яка настала природним способом.
На жаль, не всі спроби ЕКЗ виявляються успішними з першого разу. Саме тому лікарі прагнуть отримати не одну, а кілька яйцеклітин. У разі невдалої спроби через деякий час можна спробувати знову, а збережені яйцеклітини допоможуть уникнути повторення одного з найскладніших етапів штучного запліднення.
Коли показано ЕКЗ
Основним показанням до ЕКЗ є безпліддя, викликане непрохідністю маткових труб, так зване трубне безпліддя. В цьому випадку самостійно вагітність не може настати, оскільки яйцеклітина зі сперматозоїдами не здатні зустрітися, цьому перешкоджає трубна непрохідність або відсутність труб.
Інші показання:
● ановуляторні цикли — менструальні цикли, за яких зберігаються циклічні кровотечі, але не відбувається дозрівання і виходу яйцеклітини, тобто овуляції;
● ендометріоз – іноді ендометріоз призводить до розвитку спайкового процесу в маткових трубах. Спайки порушують прохідність труб, виникає вже знайоме нам трубне безпліддя.
● безпліддя неясної етіології – це стан, причину якого не вдалося встановити, попри ретельну діагностику. В цьому випадку спроба ЕКЗ — дія, що називається, наосліп, а раптом вийде й відбудеться зачаття. І справді, часто виходить.
Ефективне лікування всіх видів безпліддя пропонує медичний центр «Мати та дитина».

Варіант ЕКЗ: ІКСІ
Існують варіанти ЕКЗ, що підвищують шанси на успіх за деяких видів безпліддя. Найвідоміший з них — ІКСІ, інтраплазматична ін’єкція сперматозоїдів.
Репродуктолог, діючи під мікроскопом, спеціальною порожнистою голкою проколює оболонку яйцеклітини й вводить всередину ретельно відібраний і підготовлений сперматозоїд.
Цей метод підвищує шанси на формування ембріона, але так само як й ЕКЗ, не гарантує
імплантації його в матку. Він застосовується тоді, коли сперматозоїди не в змозі
самостійно проникнути в яйцеклітину.
До нього вдаються і в разі неуспіху попередніх спроб ЕКЗ, адже ІКСІ збільшує шанс на щасливу подію.
На правах реклами
Бажаєте читати першим найважливіші новини Луцька та Волині? Приєднуйтеся до нашого каналу в Telegram! Також за нашим сайтом можна стежити у Facebook, Google+ та Instagram.